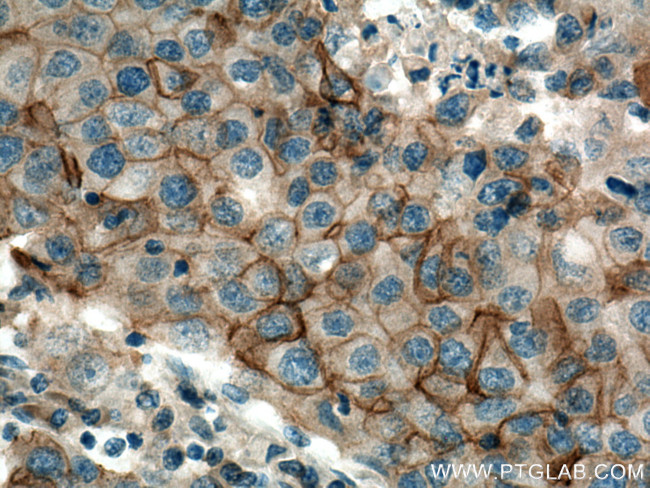
SLC12A2 Antibody in Immunohistochemistry (Paraffin) (IHC (P))

Search
Proteintech
SLC12A2 Polyclonal Antibody
{{$productOrderCtrl.translations['antibody.pdp.commerceCard.promotion.promotions']}}
{{$productOrderCtrl.translations['antibody.pdp.commerceCard.promotion.viewpromo']}}
{{$productOrderCtrl.translations['antibody.pdp.commerceCard.promotion.promocode']}}: {{promo.promoCode}} {{promo.promoTitle}} {{promo.promoDescription}}. {{$productOrderCtrl.translations['antibody.pdp.commerceCard.promotion.learnmore']}}
产品信息
28055-1-AP
种属反应
宿主/亚型
分类
类型
抗原
偶联物
形式
浓度
规格
纯化类型
保存液
内含物
保存条件
运输条件
产品详细信息
Aliquoting is unnecessary for -20°C storage.
靶标信息
NKCC1 mediates sodium and chloride transport and reabsorption. NKCC1 is a membrane protein and is important in maintaining proper ionic balance and cell volume. NKCC1 is an electrically silent transporter system that mediates sodium and chloride reabsorption. Further, NKCC1 plays a vital role in the regulation of ionic balance and cell volume and is phosphorylated in response to DNA damage. Three transcript variants encoding two different isoforms have been found for NKCC1. Diseases associated with SLC12A2 include Basosquamous Carcinoma and Metatypical Basal Cell Carcinoma.
仅用于科研。不用于诊断过程。未经明确授权不得转售。
篇参考文献 (0)
生物信息学
蛋白别名: Basolateral Na-K-Cl symporter; BSC2; bumetanide-sensitive cotransporter type 2; bumetanide-sensitive sodium-(potassium)-chloride cotransporter 1; Bumetanide-sensitive sodium-(potassium)-chloride cotransporter 2; cation-chloride cotransporter; hNKCC1; membrane electrolyte transporter; Na-K-2Cl cotransporter 1; protein phosphatase 1, regulatory subunit 141; solute carrier family 12 (sodium/potassium/chloride transporter), member 2; solute carrier family 12 (sodium/potassium/chloride transporters), member 2; Solute carrier family 12 member 2
基因别名: BSC; BSC-2; BSC2; CCC1; hNKCC1; KILQS; NKCC1; PPP1R141; SLC12A2
UniProt ID: (Human) P55011
Entrez Gene ID: (Human) 6558